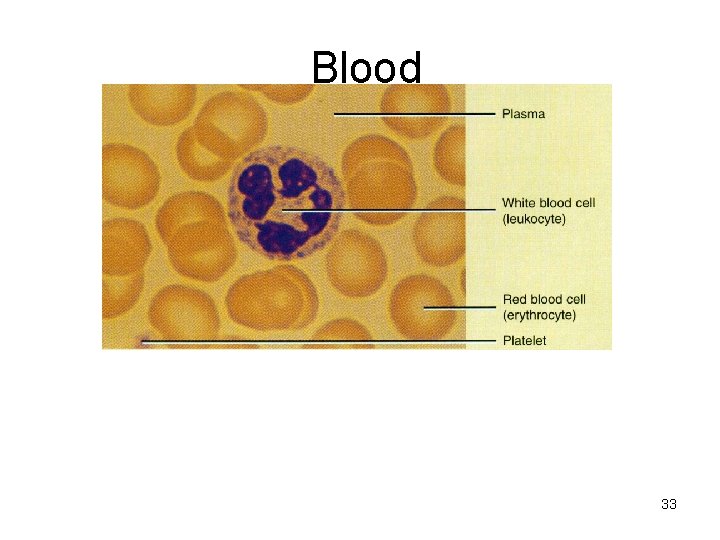
Blood 33

Tissues 1 Introduction Cells become specialized to perform

Tissues 1

Introduction • Cells become specialized to perform specific functions – Tissues are: groups of similar cells that perform the same function • • • Tissues differ from each other in: 1. size, 2. shape 3. arrangement, 4. function

4 TISSUE TYPES Four primary tissue types • 1. Epithelial tissue • 2. Connective tissue • 3. Muscle tissue • 4. Nervous tissue

EPITHELIAL TISSUE • Sheets of cells covering body surfaces or lining body cavities or structures that secrete substances • Found in: – Epidermis of skin (stratified squamous) – Lines digestive tract (stomach-rectum=simple columnar) – Walls of blood vessels (alveoli of lungs=simple sqaumous) – Inner lining of body cavities/organs/glands (sweat gland kidneys=simple cuboidal)

Epithelial Structure: # layers a. Simple epithelium – Single cell layer – Flat, irregular shape b. Stratified Epithelium – Two or more cell layers Common in high-abrasion areas – e. g. , Skin surface, mouth

Epithelial Structure: Cell Shape Cell shape • All epithelia have six sides • Cells vary in height • Three common shapes – Squamous cells – Cuboidal cells – Columnar cells – Shape of nucleus conforms to shape of cell

Muscle Tissue 1. Muscle tissue is contractile tissue 2. Provide us with motion, posture and heat 3. Muscle cell or fiber is basic unit 4. 40 -50% of body weight 5. 3 Types of muscle A. skeletal muscle B. cardiac muscle C. smooth muscle 7

Skeletal Muscle Tissue A. Covers skeleton-attached to bone B. Visible light and dark banding (looks striated) so it is called striated muscle C. Voluntary or conscious control D. Cells are long cylinders with many nuclei E. Muscle fibers contract and relax rapidly when stimulated 8

Skeletal Muscle • 9

Cardiac Muscle Tissue 1. Appearance: cells are slightly striated branched cylinders with one central nuclei, cells interlace 2. Fx: attached to and communicate with each other by intercalated discs 3. Contracts involuntarily 10

Cardiac Muscle • 11

Smooth Muscle Tissue 1. Appearance: Spindle shaped cells with a single central nuclei 2. Location: Walls of hollow organs (blood vessels, GI tract, bladder) 3. Involuntary and nonstriated 12

Smooth Muscle 13

Connective Tissue -7 types 1. Loose connective tissue 2. Elastic connective tissue 3. Adipose 4. Fibrous 5. Cartilage 6. Bone 7. Blood 14

Characteristics of Connective Tissues A. Cells far apart with a lot of intercellular material B. Intercellular material is secreted out to produce the Matrix (fibers & substances secreted by cells C. Matrix varies from liquid, gel to solid D. Has good nerve & blood supply except cartilage & tendons 15

Types of cells in Connective 1. Fibroblasts= most numerous, star-shaped. -Produce collagenous and elastic fibers found in matrix. 2. Macrophages= less numerous – engulf bacteria & debris by phagocytosis *NO FREE SIDE ON CONNECTIVE: IT IS SURROUNDED BY OTHER TISSUE OR ORGANS *NO BASEMENT MEMBRANE (ONLY ON EPITHELIAL) 16

Types of Fibers in Connective Tissue 1. Collagenous (25% of protein in your body) A. tough, resistant to pull, yet pliable B. formed from the protein collagen C. White in appearance, abundant in tendons 2. Elastic (composed of elastin) A. Very elastic B. Yellowish, called yellow fibrous tissue C. Abundant in vocal cords 17

1. Loose connective: Ak. A: areolar Appearance: 1. bundles of interlacing collagen fibers with single interlacing elastin fibers 2. Fibroblasts, macrophages, and fat cells - One of most widely distributed tissues Location in body: Fills spaces between organs and parts of organs Fx: - connects many adjacent structures in bodyacts like “elastic glue”/- “Packing tissue”- fills spaces 18

Loose Connective: Areolar • STRUCTURE: – Mixed up mess – Contains “bit” of everything • FXN: – “Packing” material 19

A. B. C. D. E. F. 2. Elastic/Yellow Elastic Connective Tissue (Characteristics) Consists mostly of elastic fibers Appear as short, kinky, hair-like threads Few cells present Has yellowish color Can be stretched Found: part of arterial walls, lung tissue, and air passages 20

Elastic Connective Tissue • Black = elastic fibers, • Pink = collagen fibers • Nuclei are mostly fibroblasts 21

Elastic Connective • Wrinkles Loss of elastin over time as you age. Skin (epithelial tissue sags over it) 22

3. Adipose Tissue (Fat) A. Fat tissue- special type of loose connective in which cells are filled with fat B. Widely distributed in body C. Appearance: large cells with a single vacuole containing a droplet of fat 23

Adipose tissue (Fat) • STRUCTURE: – Flattened nuclei – Filled with dietary fat Location: Deeper layer of skin, organ padding, yellow marrow • 3 Fxn’s: Reduces heat loss, energy storage, protection of organs 24

4. Fibrous (Dense) Connective Tissue: tendons, liagaments, fascia a. Composed largely of strong collagenous fibers (few cells) b. Arranged in wavy parallel bundles c. Matrix between bundles contain cells, rows of fibroblasts 25

Fibrous connective-cont. d. Silvery white, strong and tough e. Little elasticity (can resist tension in all directions) f. Sparingly supplied with blood vessels (slow to heal) fx: 1. form ligaments(bone to bone) (See knee model) 2. make up tendons (muscles to bone) 3. sheets cover muscles, whites of eyes , dermis of skin 26

Tendons 27

5. Cartilage a. Network of fibers in rubbery ground substance b. Flexible but firm. Does not contain minerals found in bone c. There are 3 types 28

Cartilage • Location of 3 types: 1. Elastic: ribs attach sternum, tip of nose/ears • 2. Fibro: between vertebrae • 3. Hyaline: trachea/end of long bones • STRUCTURE: – “chondrocytes” scattered in groups throughout matrix – Avascular • FX: Provide flexible support 29

30

Osseous tissue (Bone) • Good blood supply allows for fast healing from breaks/fractures 31

7. Blood -Serves as a transporting fluid- oxygen, nutrients, hormones, wastes -*Its matrix is called: plasma* - Formed by special tissue in red marrow Plasma is composed of: a. Erythrocytes- red blood cells b. Leukocytes- white blood cells c. Thrombocytes-cell fragments called platelets 32
Blood 33

Nervous th Tissue-4 type of tissue -It is sensitive to changes in surroundings. - Basic unit is the Neuron: a nucleus with long and branching cell processes a. dendrite --- carries impulses towards the cell body b. axon ---- carries impules away from the cell body • Location: brain, spinal cord, and nerves. 34

Nerve Tissue 35

Quick Quiz • 1. Give 2 of the 4 major functions of epithelial tissue. • 2. What is the difference between simple and stratified? • 3. Name 3 types of muscle tissue, give example of location for each • 4. Name two differences that exist between the different types of connective tissue 36

Quick Quiz: • 5. Name two things that all connective tissues have • 6. Explain how the anatomy of loose connective tissue relates to its physiology • 7. What is the cause of wrinkles besides the sun? • 8. Why do ACL (sprains/strains) heal slower than bone breaks? 37

• 9. What is the name for bone cells? • 10. What is name for cartilage cells? • 11. How does a neuron work? 38
- Slides: 38